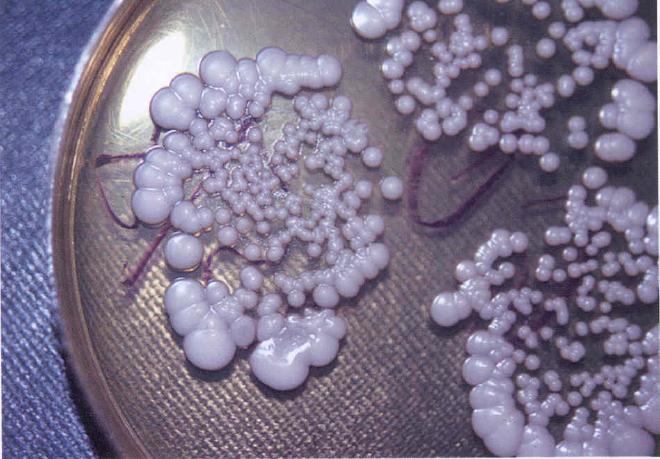
выделения

Много неприятностей причиняет женщинам кандидоз влагалища. Это инфекционное заболевание слизистой оболочки. Появляется оно в результате воздействия дрожжеподобных грибов Candida. Наличие незначительного количества этих микроорганизмов во рту, влагалище и толстой кишке считается нормой. Заболевание диагностируется, если грибы начинают размножаться в большом количестве. Происходит это в большей мере по причине снижения иммунитета.
Что такое вагинальный кандидоз?

Вагинальный кандидоз – это всем известная молочница, которая многим представительницам прекрасного пола приносит достаточно неприятностей и хлопот. Эти дрожжеподобные грибы не настолько сильны, чтобы атаковать женский организм с крепкой иммунной системой. Но, как только в женском организме происходит сбой работы иммунной системы, грибы тут же дают о себе знать своими массовыми поселениями в области урогенитального тракта.
Основной характеристикой данного заболевания есть его упорное течение в хронической форме. Не всегда лечение противогрибковыми средствами приносит свои положительные результаты.
В чем суть особенности вагинального кандидоза и какие существуют эффективные методы его лечения? Эти вопросы являются актуальными для многих женщин.
Кандидоз у женщин, также известный как молочница, представляет собой грибковую инфекцию, вызванную избыточным размножением грибов рода Candida, чаще всего Candida albicans. Врачи отмечают, что данное заболевание проявляется зудом, жжением, а также характерными выделениями, которые могут иметь творожистую консистенцию. Основными факторами, способствующими развитию кандидоза, являются ослабленный иммунитет, гормональные изменения, а также длительный прием антибиотиков. Специалисты подчеркивают важность своевременной диагностики и лечения, так как игнорирование симптомов может привести к хроническим формам заболевания. Врачами рекомендуется поддерживать баланс микрофлоры, соблюдать правила личной гигиены и избегать избыточного потребления сахара, что может помочь в профилактике кандидоза.
https://youtube.com/watch?v=686jxhZ4P94
Факторы, влияющие на появление кандидоза
Существует несколько разновидностей этого условно-патогенного гриба. Многие из них проявляют устойчивость ко многим общепринятым противогрибковым лекарствам. Этим объясняются довольно частые неудачные попытки лечения молочницы вагинальной.
Строение женского тела имеет некоторые особенности, которые являются закрытыми воротами для многих влагалищных инфекций. У здоровой женщины:

Гормональный фон у здоровой женщины способствует поддержанию у нее нормального pH. В такой среде нет места для болезнетворных микроорганизмов.
Серьезные проблемы появляются при снижении иммунитета или изменении гормонального фона. Это происходит по разным причинам:
Причиной кандидоза может выступить неправильное, несбалансированное питание женщины.
Симптомы кандидоза
Кандидоз настолько специфически и явно проявляется, что у врачей не возникает больших трудностей при постановке диагноза. Достаточно часто женщины сами определяют у себя это заболевание и пытаются излечиться от него самостоятельно, что недопустимо и чревато серьезными последствиями.

Существуют такие признаки кандидоза:
Иногда заболевание проходит в атипичной форме. В этих случаях симптомы вагинального кандидоза менее выражены, женщина узнает о заболевании только при профессиональном осмотре. Поэтому очень важно каждой женщине проходить медосмотр раз в год.
Вагинальный кандидоз – это заболевание, которое нередко сопровождает скрытые инфекции, передающиеся половым путем. Только после квалифицированной консультации врача, сдачи всех необходимых анализов ставится конечный диагноз и назначается эффективное лечение. Диагностировать у себя заболевание самостоятельно невозможно. Самолечение опасно серьезными осложнениями.
Кандидоз у женщин — это распространенное заболевание, вызванное избыточным размножением грибка рода Candida, чаще всего Candida albicans. Многие женщины сталкиваются с этой проблемой, и мнения о ней варьируются. Некоторые считают кандидоз лишь временным дискомфортом, который легко лечится, в то время как другие подчеркивают, что это может быть признаком серьезных нарушений в организме. Симптомы, такие как зуд, жжение и необычные выделения, вызывают беспокойство и приводят к поиску медицинской помощи. Важно отметить, что кандидоз может возникать на фоне стресса, гормональных изменений или неправильного питания. Женщины делятся опытом, как они справлялись с этой проблемой, и многие отмечают, что профилактика, включая соблюдение гигиенических норм и здоровый образ жизни, играет ключевую роль в предотвращении рецидивов.
https://youtube.com/watch?v=6YscvCl77uI
Первые признаки
Каждая женщина должна насторожиться при появлении таких признаков:
В основном первая симптоматика дает о себе знать за 7 дней до начала месячных. Все неприятные ощущения усиливаются после теплых водных процедур. Они проявляются настолько сильно, что женщине трудно уснуть. Не нужно медлить и ждать появления других симптомов. Вышеперечисленных признаков достаточно для повода обратиться к врачу.
Диагностика
Наличие грибов в мазке подтверждается с помощью микробиологического исследования. Кроме этого, врач с помощью зеркала осматривает половые органы, проверяет насколько гиперемированная и отечная слизистая оболочка влагалища, а также насколько много творожистых выделений.
Окрас раствора Люголя дает картину мелкоточечных вкраплений и выраженного сосудистого рисунка. Бакпосев определяет наличие большого количества белых колоний микроорганизмов с округлыми формами. Иногда для подтверждения точного диагноза необходим бакпосев мочи, анализ мазка из уретры, кровь на сахар.
Лечение

В борьбе с грибом Candida необходим комплексный подход. Важно изначально прекратить активность и рост патогенных грибов с помощью противогрибковых препаратов для внутреннего и наружного применения антимикотиков.
В настоящее время существует большой выбор лекарственных средств от кандидоза во влагалище. Но, несмотря на это разнообразие нельзя заниматься самолечением. Все течение заболевания должно находиться под строгим контролем врача. Он назначает лечение и контролирует состояние женщины.
Таблетки от молочницы
Флуконазол – отлично зарекомендовавшее себя от грибковых заболеваний средство. Его особенная эффективность проявляется в начальной стадии заболевания, при появлении первой симптоматики. Интраконазол является еще одним отличным средством при данной проблеме. Хорошо зарекомендовали себя в борьбе с молочницей также Клотримазол, Миконазол, Изоконазол. Эти методы врачи рекомендуют в случае, если наружное лечение молочницы не принесло положительных результатов или кандидоз имеет частые рецидивы. Беременным женщинам и кормящим грудью данные лекарства противопоказаны.
Свечи и кремы от молочницы
Свечами и кремами лечится половой кандидоз во время беременности и лактации. В основном эти средства применяются перед сном. Свечи вводятся в вагину, а кремом или мазью обрабатывается вся ее поверхность изнутри и снаружи. Курс лечения продолжается еще некоторое время после исчезновения симптомов. Из свечей стоит отметить Залаин, Клион-Д 100, Кандид В6 и др.

Народные средства
С помощью народных рецептов невозможно полностью избавиться от кандидоза. Их чаще всего используют как вспомогательные средства. С их помощью снижается воспалительный процесс во влагалище, восстанавливается его микрофлора. Рекомендуется во время заболевания больше употреблять чеснока и лука, которые являются отличным природным противомикробным средством. Прекрасно помогают в лечении вируса кандида настои из ромашки, календулы, шалфея, можжевельника, эвкалипта. Для подмывания часто используется корень лопуха, календула, зверобой или дубовая кора.
Рекомендуемая диета
Любое серьезное заболевание требует корректировки в меню. Некоторые продукты становятся очень полезными, а некоторые причиняют непоправимый вред. Во время лечения кандидоза важно ограничиться в употреблении таких продуктов:
Очень полезны во время лечения йогурты, содержащие активные бактерии. Их регулярное потребление способствует быстрому выздоровлению.
Последствия молочницы

Есть два варианта последствий этого неприятного женского заболевания:
- Лечение острого течения болезни было начато своевременно. Женщиной были соблюдены все правила и рекомендации лечащего врача. С помощью эффективных и проверенных препаратов существует большая вероятность того, что от молочницы избавляются полностью и без негативных последствий потому, что у большинства лекарств от молочницы побочные эффекты незначительные.
- Неправильное лечение острой молочницы и несвоевременное обращение к врачу серьезно усугубляет ситуацию и способствует переходу молочницы в хроническую форму, что представляет собой большие сложности в последующем лечении и возникновение серьезных осложнений.
Осложнения хронической молочницы
Из статистических данных известно, что редко хроническая форма молочницы проходит без последствий.
Приблизительно в 70% из 100 подобных случаев наблюдаются такие осложнения:
Для полного излечения от вагинального кандидоза важно не только принимать препараты, назначенные врачом, но и принимать все меры для повышения иммунитета, соблюдать правила интимной гигиены, нормализовать питание, стараться избегать всех факторов, провоцирующих молочницу.
После прохождения курса лечения и исчезновения симптомов необходимо посетить врача и убедиться в полном выздоровлении.
https://youtube.com/watch?v=IFuHYfWk12U
Вопрос-ответ
Отчего бывает кандидоз у женщин?
Спровоцировать кандидоз могут тонзиллит, цирроз печени, гормональная терапия, ожирение, сахарный диабет, беременность, анорексия, резкая смена климата, длительное лечение антибиотиками. Особую роль в развитии молочницы влагалища могут играть и такие факторы, как несоблюдение личной гигиены.
Чем лечится кандидоз у женщин?
Среди наиболее популярных препаратов при вагинальном кандидозе — флукостат, флуконазол (пероральные таблетки), клотримазол (вагинальные таблетки или крем), пимафуцин (свечи) и множество других лекарств. Подобрать оптимальную для вас схему лечения должен врач.
Советы
СОВЕТ №1
Обратите внимание на симптомы. Кандидоз может проявляться зудом, жжением, белыми выделениями и дискомфортом. Если вы заметили эти признаки, не откладывайте визит к врачу для диагностики и назначения лечения.
СОВЕТ №2
Соблюдайте гигиену. Регулярное соблюдение правил личной гигиены, использование дышащего нижнего белья и избегание синтетических тканей могут помочь предотвратить развитие кандидоза.
СОВЕТ №3
Следите за своим питанием. Употребление продуктов, богатых пробиотиками, таких как йогурт и кефир, может поддерживать баланс микрофлоры и снижать риск кандидоза. Ограничьте потребление сахара, так как он способствует росту грибков.
СОВЕТ №4
Избегайте самолечения. Не занимайтесь самолечением и не используйте препараты без назначения врача. Неправильное лечение может усугубить проблему и привести к хроническому кандидозу.










